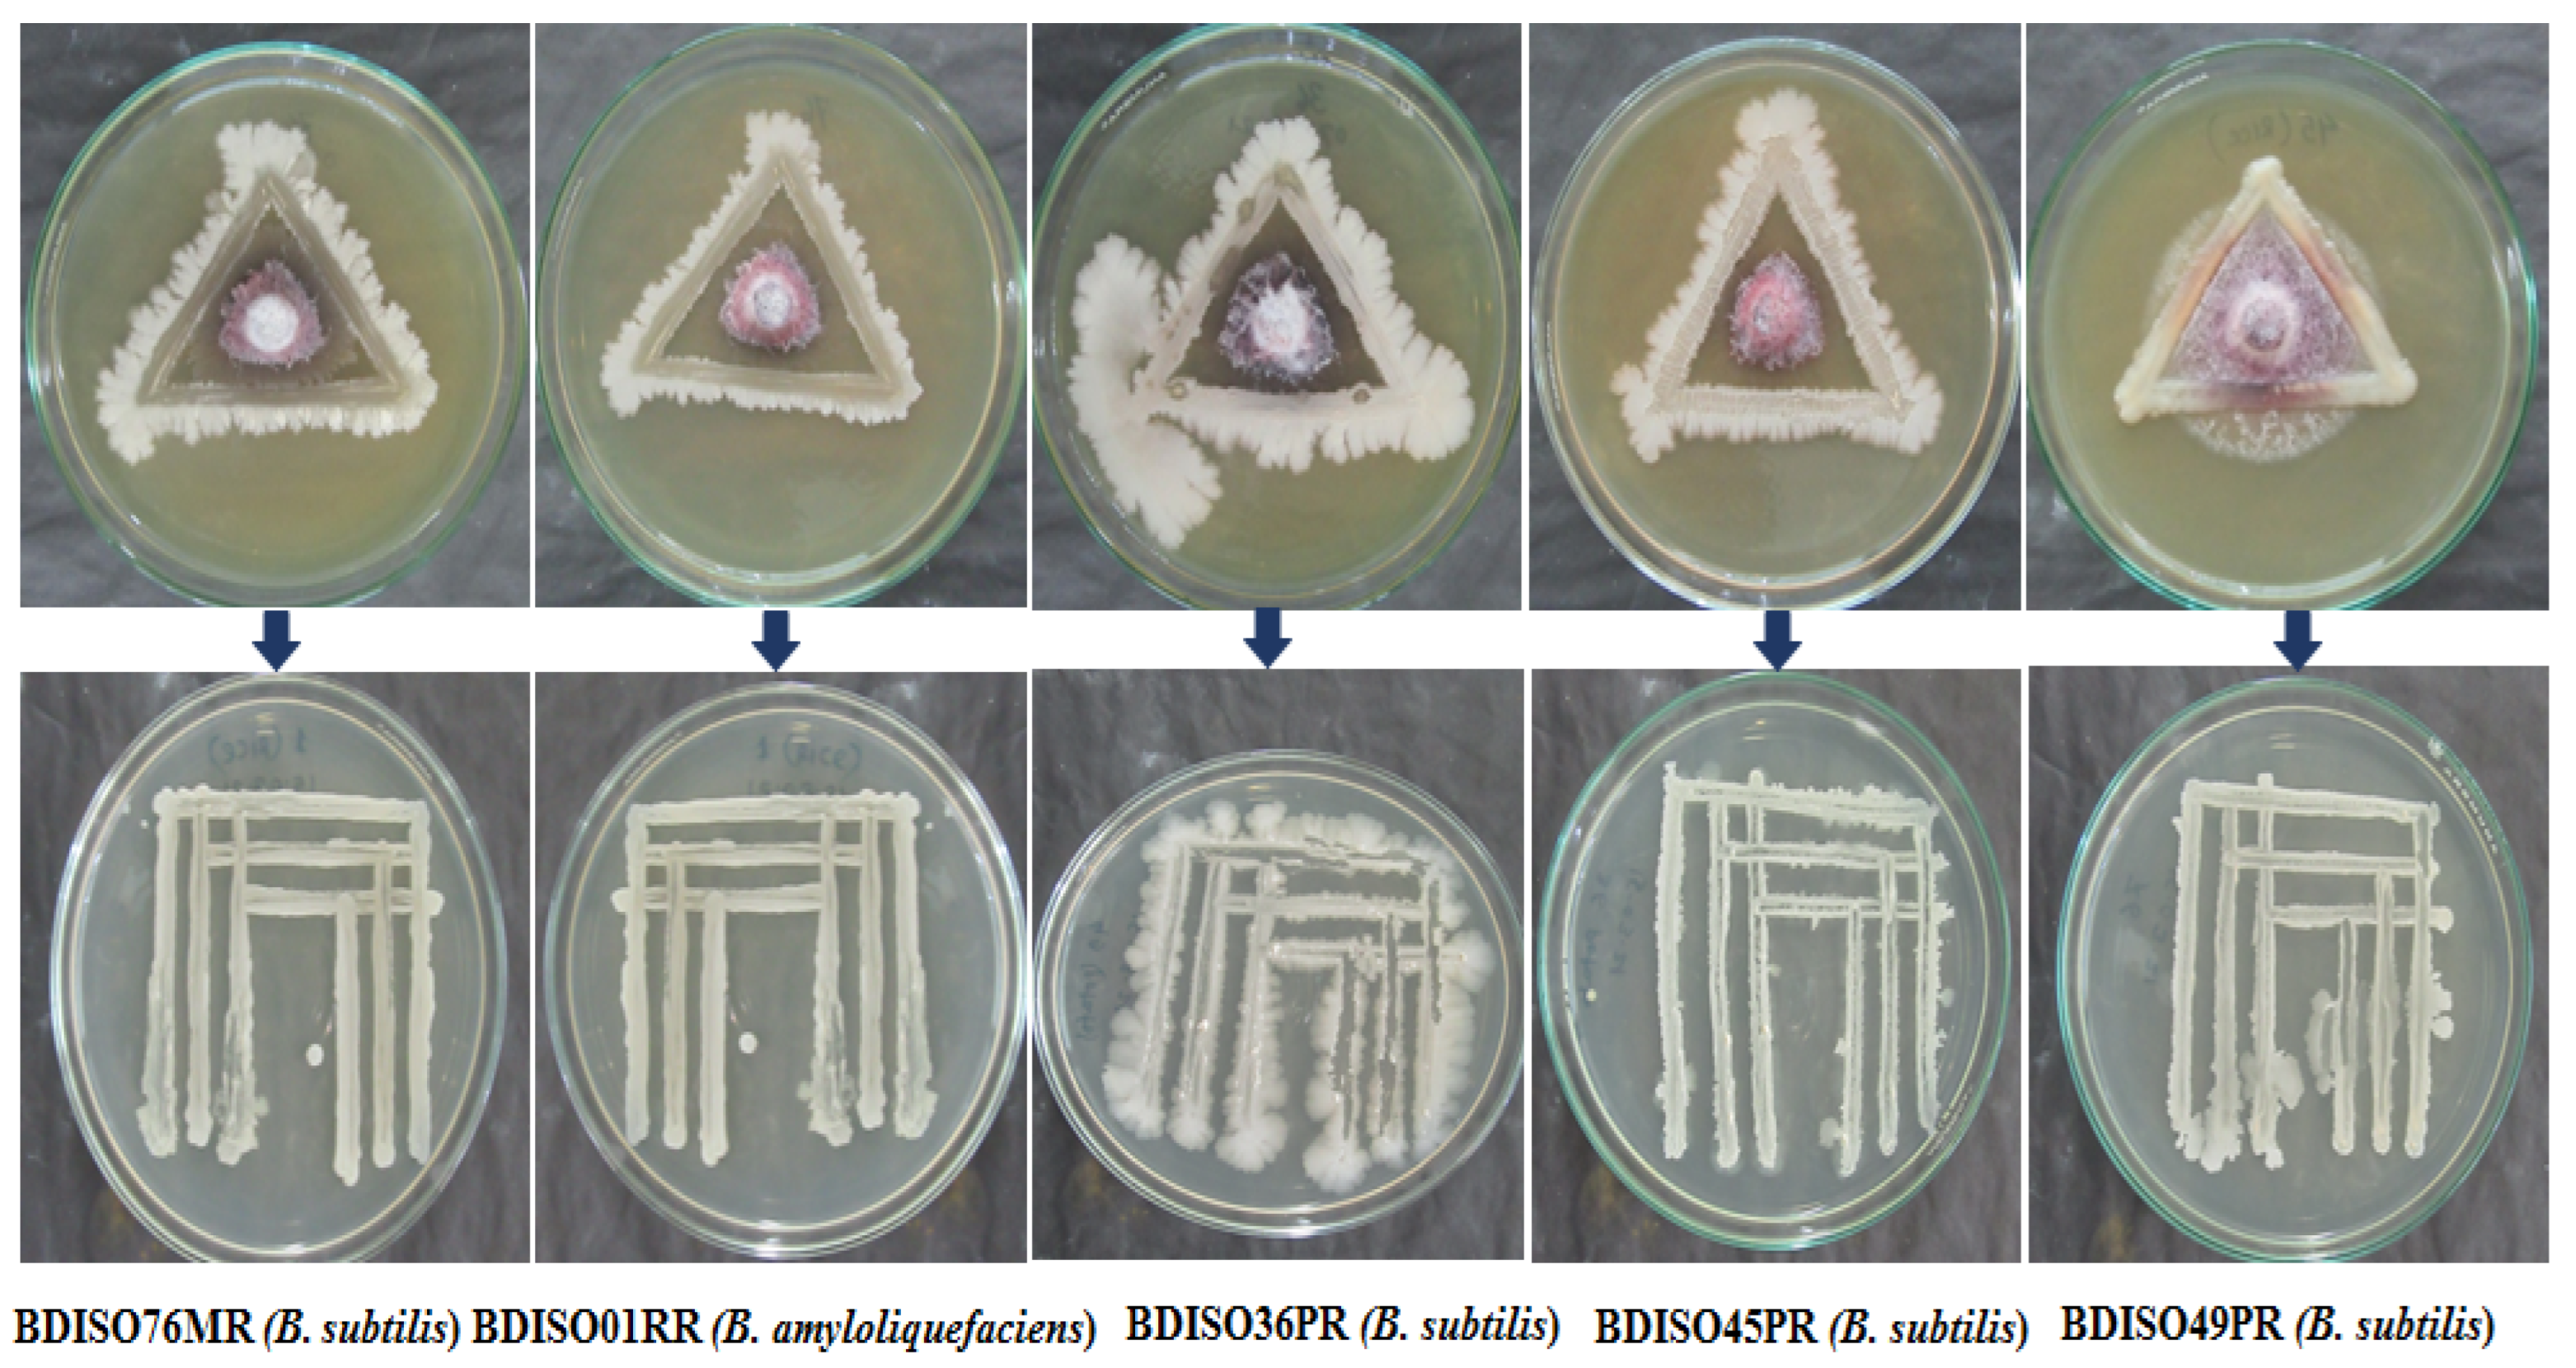
Agronomy 12 02608 g001 Agronomy 12 02608 g001

Potential Native Bacilli Reduce Fumonisin Contamination in Maize
Abstract
1. Introduction
2. Materials and Methods
2.1. Bacterial Isolates and Culture Condition
2.2. Isolation and Purification of Bacterial Isolates from Maize Rhizosphere
2.3. In Vitro Growth Inhibition of F. Proliferatum by Bacterial Isolates
2.4. Identification of Bacillus Species from Maize Rhizosphere
2.5. Identification of Potential F. Proliferatum by In Vitro Inoculation
2.5.1. Inoculum Preparation of F. Proliferatum
2.5.2. In Vitro Inoculation of F. Proliferatum with Maize Grain
2.6. Co-i of Maize Grains with F. Proliferatum and Different Bacillus Species
2.7. Determination of Total Fumonisin
2.8. Detection of Colony-Forming Units (CFUs) of F. proliferatum
2.9. Assessment of Plant Growth Promotion
2.9.1. Preparation of Suspension and Seed Treatment
2.9.2. Growth Promotion and Root Colonization Assay
3. Results
3.1. Identification of Potential F. Proliferatum
3.2. In Vitro Antagonistic Activity of Bacillus Species against F. Proliferatum
3.3. PCR-Based Identification of Bacillus Species from Maize Rhizosphere
3.4. Effect of Bacillus Species on the Reduction o Fumonisin Accumulation in Co-Inoculated Maize Grains
3.5. Influence of Bacillus Species on the Reduction of F. proliferatum Population in Co-Inoculated Maize Grains
3.6. Correlation between Fumonisin Concentration and Population of F. Proliferatum
3.7. Root Colonization of Different Bacillus Species in the Maize Rhizosphere
3.8. Influence of Different Bacillus sp. on Average Root and Shoot Length and Vigor Index
4. Discussion
5. Conclusions
Supplementary Materials
Author Contributions
Funding
Institutional Review Board Statement
Informed Consent Statement
Data Availability Statement
Acknowledgments
Conflicts of Interest
References
- OGTR (Australian Government Office of the Gene Technology Regulator). The Biology of Zea mays L. spp. mays (Maize or Corn). Australia; 2008. Available online: https://www.ogtr.gov.au/resources/publications/biology-zea-mays-l-ssp-mays-maize-or-corn (accessed on 1 August 2022).
- BBS. Statistical Pocket Book of Bangladesh; Bangladesh Bureau of Statistics, Planning Division, Ministry of Planning, Government of the Peoples Republic of Bangladesh: Dhaka, Bangladesh, 2020. [Google Scholar]
- Shephard, G.S. Aflatoxin and Food Safety: Recent African Perspectives. J. Toxicol. Toxin Rev. 2003, 22, 267–286. [Google Scholar] [CrossRef]
- Jannat, M.; Masud, M.; Nusrat, M.; Bashar, S.; Mita, M.M.; Hossain, M.I.; Alam, Z.; Yeasmin, S.; Islam, R. Aflatoxins and Fumonisins Contamination of Maize in Bangladesh: An Emerging Threat for Safe Food and Food Security. In Maize Genetic Resources: Breeding Strategies and Recent Advances; El-Esawi, M.A., Ed.; IntechOpen: London, UK, 2022; pp. 18–69. [Google Scholar] [CrossRef]
- Gruber-Dorninger, C.; Jenkins, T.; Schatzmayr, G. Global mycotoxin occurrence in feed: A ten-year survey. Toxins 2019, 11, 375. [Google Scholar] [CrossRef] [PubMed]
- Kyei, N.N.A.; Cramer, B.; Humpf, H.-U.; Degen, G.H.; Ali, N.; Gabrysch, S. Assessment of multiple mycotoxin exposure and its association with food consumption: A human biomonitoring study in a pregnant cohort in rural Bangladesh. Arch. Toxicol. 2022, 96, 2123–2138. [Google Scholar] [CrossRef] [PubMed]
- Haschek, W.M.; Gumprecht, L.A.; Smith, G.; Tumbleson, M.E.; Constable, P.D. Fumonisin toxicosis in swine: An overview of porcine pulmonary edema and current perspectives. Environ. Health Perspect. 2001, 109 (Suppl. S2), 251–257. [Google Scholar] [PubMed]
- Marasas, W.F.O.; Kellerman, T.S.; Gelderblom, W.C.; Thiel, P.G.; Van der Lugt, J.J.; Coetzer, J.A. Leukoencephalomalacia in a horse induced by fumonisin B₁ isolated from Fusarium moniliforme. Onderstepoort J. Vet. Res. 1988, 55, 197–203. [Google Scholar] [PubMed]
- Rheeder, J.P.; Marasas, W.F.; Thiel, P.G.; Sydenham, E.W.; Shephard, G.S.; Van Schalkwyk, D.J. Fusarium moniliforme and fumonisins in corn in relation to human esophageal cancer in Transkei. Phytopathology 1992, 82, 353–357. [Google Scholar] [CrossRef]
- Missmer, S.A.; Suarez, L.; Felkner, M.; Wang, E.; Merrill, A.H., Jr.; Rothman, K.J.; Hendricks, K.A. Exposure to fumonisins and the occurrence of neural tube defects along the Texas–Mexico border. Environ. Health Perspect. 2006, 114, 237–241. [Google Scholar] [CrossRef] [PubMed]
- Magoha, H.; De Meulenaer, B.; Kimanya, M.; Hipolite, D.; Lachat, C.; Kolsteren, P. Fumonisin B1 contamination in breast milk and its exposure in infants under 6 months of age in Rombo, Northern Tanzania. Food Chem. Toxicol. 2014, 74, 112–116. [Google Scholar] [CrossRef]
- Michaelsen, K.F. Feeding and Nutrition of Infants and Young Children: Guidelines for the WHO European Region, with Emphasis on the Former Soviet Countries (No. 87); WHO Regional Office Europe: Copenhagen, Denmark, 2000. [Google Scholar]
- Kimanya, M.E.; Shirima, C.P.; Magoha, H.; Shewiyo, D.H.; De Meulenaer, B.; Kolsteren, P.; Gong, Y.Y. Co-exposures of aflatoxins with deoxynivalenol and fumonisins from maize based complementary foods in Rombo, Northern Tanzania. Food Control 2014, 41, 76–81. [Google Scholar] [CrossRef]
- UlHaq, I.; Sarwar, M.K.; Faraz, A.; Latif, M.Z. Synthetic chemicals: Major component of plant disease management. In Plant Disease Management Strategies for Sustainable Agriculture through Traditional and Modern Approaches; Springer: Cham, Switzerland, 2020; Volume 13, pp. 53–81. [Google Scholar]
- Murugesan, P.; Brunda, D.K.; Moses, J.A.; Anandharamakrishnan, C. Photolytic and photocatalytic detoxification of mycotoxins in foods. Food Control 2001, 123, 107748. [Google Scholar] [CrossRef]
- Hammond, B.G.; Campbell, K.W.; Pilcher, C.D.; Degooyer, T.A.; Robinson, A.E.; McMillen, B.L.; Spangler, S.M.; Riordan, S.G.; Rice, L.G.; Richard, J.L. Lower Fumonisin Mycotoxin Levels in the Grain of Bt Corn Grown in the United States in 2000−2002. J. Agric. Food Chem. 2004, 52, 1390–1397. [Google Scholar] [CrossRef]
- Lanubile, A.; Ferrarini, A.; Maschietto, V.; Delledonne, M.; Marocco, A.; Bellin, D. Functional genomic analysis of constitutive and inducible defense responses to Fusarium verticillioides infection in maize genotypes with contrasting ear rot resistance. BMC Genom. 2014, 15, 710. [Google Scholar] [CrossRef]
- Munkvold, G.P. Cultural and genetic approaches to managing mycotoxins in maize. Annu. Rev. Phytopathol. 2003, 41, 99–116. [Google Scholar] [CrossRef]
- Ongena, M.; Jacques, P. Bacillus lipopeptides: Versatile weapons for plant disease biocontrol. Trends Microbiol. 2008, 16, 115–125. [Google Scholar] [CrossRef]
- Etcheverry, M.G.; Scandolara, A.; Nesci, A.; Vilas Boas Ribeiro, M.S.; Pereira, P.; Battilani, P. Biological interactions to select biocontrol agents against toxigenic strains of Aspergillus flavus and Fusarium verticillioides from maize. Mycopathologia 2009, 167, 287–295. [Google Scholar] [CrossRef]
- Hashem, A.; Tabassum, B.; Abd_Allah, E.F. Bacillus subtilis: A plant-growth promoting rhizobacterium that also impacts biotic stress. Saudi J. Biol. Sci. 2019, 26, 1291–1297. [Google Scholar] [CrossRef]
- Hernández-Morales, A.; Martínez-Peniche, R.A.; Arvizu-Gómez, J.L.; Arvizu-Medrano, S.M.; Rodríguez-Ontiveros, A.; Ramos-López, M.A.; Pacheco-Aguilar, J.R. Production of a Mixture of Fengycins with Surfactant and Antifungal Activities by Bacillus sp. MA04, a Versatile PGPR. Indian J. Microbiol. 2018, 58, 208–213. [Google Scholar] [CrossRef]
- Cavaglieri, L.; Orlando, J.R.M.I.; Rodriguez, M.I.; Chulze, S.; Etcheverry, M. Biocontrol of Bacillus subtilis against Fusarium verticillioides in vitro and at the maize root level. Res. Microbiol. 2005, 156, 748–754. [Google Scholar] [CrossRef]
- Guimarães, R.A.; Zanotto, E.; Perrony, P.E.P.; Zanotto, L.A.S.; da Silva, L.J.; Machado, J.D.C.; Pinto, F.A.M.F.; Medeiros, H.N.; von Pinho, R.G.; de Melo, I.S.; et al. Integrating a chemical fungicide and Bacillus subtilis BIOUFLA2 ensures leaf protection and reduces ear rot (Fusarium verticillioides) and fumonisin content in maize. J. Phytopathol. 2021, 169, 139–148. [Google Scholar] [CrossRef]
- Dukare, A.; Paul, S. Biological control of Fusarium wilt and growth promotion in pigeon pea (Cajanus cajan) by antagonistic rhizobacteria, displaying multiple modes of pathogen inhibition. Rhizosphere 2021, 17, 100278. [Google Scholar] [CrossRef]
- Ju, R.; Zhao, Y.; Li, J.; Jiang, H.; Liu, P.; Yang, T.; Bao, Z.; Zhou, B.; Zhou, X.; Liu, X. Identification and evaluation of a potential biocontrol agent, Bacillus subtilis, against Fusarium sp. in apple seedlings. Ann. Microbiol. 2014, 64, 377–383. [Google Scholar] [CrossRef]
- Bacon, C.W.; Yates, I.E.; Hinton, D.M.; Meredith, F. Biological control of Fusarium moniliforme in maize. Environ. Health Perspect. 2001, 109 (Suppl. S2), 325–332. [Google Scholar]
- Al-Masri, S.A.; El-Safty, S.M.; Nada, S.A.; Amra, H.A. Saccharomyces cerevisiae and probiotic bacteria potentially inhibit fumonisin B1 production in vitro and in vivo. J. Am. Sci. 2011, 7, 198–205. [Google Scholar]
- Rahman, M.M.; Masud, M.M.; Hossain, M.I.; Islam, N.; Alam, M.Z.; Rashid, M.M.; Khan, M.A.I.; Latif, M.A.; Halder, K.P.; Islam, M.R. Potential Role of Rice Plant Growth Promoting Phylloplane and Rhizospheric Bacteria in Controlling Xanthomonas oryzae pv. oryzae. In Integrative Advances in Rice Research; IntechOpen: London, UK, 2021. [Google Scholar]
- Islam, M.H.; Masud, M.M.; Jannat, M.; Hossain, M.I.; Islam, S.; Alam, M.Z.; Serneels, F.J.B.; Islam, M.R. Potentiality of Formulated Bioagents from Lab to Field: A Sustainable Alternative for Minimizing the Use of Chemical Fungicide in Controlling Potato Late Blight. Sustainability 2022, 14, 4383. [Google Scholar] [CrossRef]
- Liu, Y.; Teng, K.; Wang, T.; Dong, E.; Zhang, M.; Tao, Y.; Zhong, J. Antimicrobial Bacillus velezensis HC6: Production of three kinds of lipopeptides and biocontrol potential in maize. J. Appl. Microbiol. 2020, 128, 242–254. [Google Scholar] [CrossRef]
- He, Y.; Zhu, M.; Huang, J.; Hsiang, T.; Zheng, L. Biocontrol potential of a Bacillus subtilis strain BJ-1 against the rice blast fungus Magnaporthe oryzae. Can. J. Plant Pathol. 2019, 41, 47–59. [Google Scholar] [CrossRef]
- Figueroa-López, A.M.; Cordero-Ramírez, J.D.; Martínez-Álvarez, J.C.; López-Meyer, M.; Lizárraga-Sánchez, G.J.; Félix-Gastélum, R.; Castro-Martínez, C.; Maldonado-Mendoza, I.E. Rhizospheric bacteria of maize with potential for biocontrol of Fusarium verticillioides. SpringerPlus 2016, 5, 330. [Google Scholar] [CrossRef]
- Xie, S.; Jiang, L.; Wu, Q.; Wan, W.; Gan, Y.; Zhao, L.; Wen, J. Maize Root Exudates Recruit Bacillus amyloliquefaciens OR2-30 to Inhibit Fusarium graminearum Infection. Phytopathology 2022, 112, 1886–1893. [Google Scholar] [CrossRef]
- Hanif, A.; Zhang, F.; Li, P.; Li, C.; Xu, Y.; Zubair, M.; Zhang, M.; Jia, D.; Zhao, X.; Liang, J.; et al. Fengycin Produced by Bacillus amyloliquefaciens FZB42 Inhibits Fusarium graminearum Growth and Mycotoxins Biosynthesis. Toxins 2019, 11, 295. [Google Scholar] [CrossRef]
- Lei, S.; Zhao, H.; Pang, B.; Qu, R.; Lian, Z.; Jiang, C.; Shao, D.; Huang, Q.; Jin, M.; Shi, J. Capability of iturin from Bacillus subtilis to inhibit Candida albicans in vitro and in vivo. Appl. Microbiol. Biotechnol. 2019, 103, 4377–4392. [Google Scholar] [CrossRef]
- Lizárraga-Sánchez, G.J.; Leyva-Madrigal, K.Y.; Sánchez-Peña, P.; Quiroz-Figueroa, F.R.; Maldonado-Mendoza, I.E. Bacillus cereus sensulato strain B25 controls maize stalk and ear rot in Sinaloa, Mexico. Field Crops Res. 2015, 176, 11–21. [Google Scholar] [CrossRef]
- Guo, Z.; Zhang, X.; Wu, J.; Yu, J.; Xu, M.; Chen, D.; Zhang, Z.; Li, X.; Chi, Y.; Wan, S. In Vitro inhibitory effect of the bacterium Serratia marcescens on Fusarium proliferatum growth and fumonisins production. Biol. Control 2020, 143, 104188. [Google Scholar] [CrossRef]
- Cai, B.P.; Chen, J.Y.; Zhang, Q.X.; Guo, L.D. A survey of arbuscular mycorrhizal colonization in roots of Prunus mume in China. Acta Hortic. Sin. 2008, 35, 599. [Google Scholar]
- Köhl, J.; Kolnaar, R.; Ravensberg, W.J. Mode of action of microbial biological control agents against plant diseases: Relevance beyond efficacy. Front. Plant Sci. 2019, 10, 845. [Google Scholar] [CrossRef]
- Bevivino, A.; Sarrocco, S.; Dalmastri, C.; Tabacchioni, S.; Cantale, C.; Chiarini, L. Characterization of a free-living maize-rhizosphere population of Burkholderia cepacia: Effect of seed treatment on disease suppression and growth promotion of maize. FEMS Microbiol. Ecol. 1998, 27, 225–237. [Google Scholar] [CrossRef]
- Bais, H.P.; Fall, R.; Vivanco, J.M. Biocontrol of Bacillus subtilis against infection of Arabidopsis roots by Pseudomonas syringae is facilitated by biofilm formation and surfactin production. Plant Physiol. 2004, 134, 307–319. [Google Scholar] [CrossRef]
- Ndeddy Aka, R.J.; Babalola, O.O. Effect of bacterial inoculation of strains of Pseudomonas aeruginosa, Alcaligenes feacalis and Bacillus subtilis on germination, growth and heavy metal (Cd, Cr, and Ni) uptake of Brassica juncea. Int. J. Phytoremediat. 2016, 18, 200–209. [Google Scholar] [CrossRef]
- Chen, X.H.; Koumoutsi, A.; Scholz, R.; Eisenreich, A.; Schneider, K.; Heinemeyer, I.; Morgenstern, B.; Voss, B.; Hess, W.R.; Reva, O.; et al. Comparative analysis of the complete genome sequence of the plant growth–promoting bacterium Bacillus amyloliquefaciens FZB42. Nat. Biotechnol. 2007, 25, 1007–1014. [Google Scholar] [CrossRef]
- Li, S.; Zhang, N.; Zhang, Z.; Luo, J.; Shen, B.; Zhang, R.; Shen, Q. Antagonist Bacillus subtilis HJ5 controls Verticillium wilt of cotton by root colonization and biofilm formation. Biol. Fertil. Soils 2013, 49, 295–303. [Google Scholar] [CrossRef]
- Shafi, J.; Tian, H.; Ji, M. Bacillus species as versatile weapons for plant pathogens: A review. Biotechnol. Biotechnol. Equip. 2017, 31, 446–459. [Google Scholar] [CrossRef]
- Ahn, I.-P.; Park, K.; Kim, C.-H. Rhizobacteria-induced resistance perturbs viral disease progress and triggers defense-related gene expression. Mol. Cells 2002, 13, 302–308. [Google Scholar]
- Georgelis, N.; Nikolaidis, N.; Cosgrove, D.J. Biochemical analysis of expansin-like proteins from microbes. Carbohydr. Polym. 2014, 100, 17–23. [Google Scholar] [CrossRef] [PubMed]

| Treatments | Radial Mycelial Growth of F. proliferatum (mm) 1 | % Reduction of Radial Mycelial Growth Overcontrol | ||
|---|---|---|---|---|
| Days after Inoculation (DAI) | ||||
| 4 | 7 | 4 | 7 | |
| Control | 31 ± 1 a | 80 ± 0.00 a | 0 | 0 |
| Negative control | 24.5 ± 2.5 ab | 42 ± 2.5 b | 20.63 | 47.5 |
| BDISO76MR | 9.25 ± 0.75 d | 11.75 ± 0.75 d | 70.21 | 85.31 |
| BDISO01RR | 12 ± 1.00 cd | 12 ± 1.00 cd | 61.15 | 85 |
| BDISO45PR | 12.25 ± 0.75 cd | 12.25 ± 0.75 cd | 60.52 | 84.69 |
| BDISO36PR | 14 ± 0.5 cd | 14 ± 0.5 cd | 54.84 | 82.5 |
| BDISO49PR | 18 ± 0.00 bc | 18 ± 0.00 c | 41.88 | 77.5 |
| Level of significance * | * | * | - | - |
| LSD | 3.92 | 3.71 | - | - |
| CV% | 0.08 | 0.04 | - | - |
| Treatments | Fumonisin Concentration (ppm) 1 | % Reduction of Fumonisin Concentration | ||||
|---|---|---|---|---|---|---|
| Days after Inoculation (DAI) | ||||||
| 10 | 20 | 35 | 10 | 20 | 35 | |
| Positive control | 4.93 ± 0.43 a | 5.56 + 0.43 a | 20.32 ± 0.43 a | 0 | 0 | 0 |
| BDISO01RR | 3.15 ± 0.43 ab | 3.11 ± 0.43 bc | 3.11 ± 0.43 c | 36.11 | 44.12 | 84.70 |
| BDISO36PR | 1.7 ± 0.43 bc | 1.69 ± 0.43 bc | 3.38 ± 0.43 bc | 65.52 | 69.56 | 83.36 |
| BDISO45PR | 3.42 ± 0.43 ab | 3.42 ± 0.43 b | 4.29 ± 0.43 bc | 30.63 | 38.53 | 78.90 |
| BDISO49PR | 3.72 ± 0.43 ab | 1.36 ± 0.43 bc | 5.41 ± 0.43 b | 24.54 | 75.48 | 73.36 |
| BDISO76MR | 0.9 ±0.43 c | 1.29 ± 0.43 c | 3.02 ± 0.43 c | 81.74 | 76.81 | 85.12 |
| Level of significance * | * | * | * | - | - | - |
| LSD | 1.31 | 1.31 | 1.31 | - | - | - |
| CV% | 0.27 | 0.28 | 0.12 | - | - | - |
| Treatments | The Population of F. proliferatum (CFU/g Maize Grain) 1 | ||
|---|---|---|---|
| Days after Inoculation (DAI) | |||
| 10 | 20 | 35 | |
| Positive control | 9.4 × 104 ± 0.64 ab | 10 × 104 ± 0.77 c | 5.5 × 104 ± 0.43 b |
| BDISO01RR | 12.2 × 104 ± 0.64 a | 13.3 × 104 ± 0.77 b | 1.1 × 104 ± 0.43 a |
| BDISO36PR | 7.2 × 104 ± 0.64 b | 16.1 × 104 ± 0.77 a | 1.1 × 104 ± 0.43 a |
| BDISO45PR | 8.8 × 104 ± 0.64 b | 4.4 × 104 ± 0.77 e | 1.1 × 104 ± 0.43 a |
| BDISO49PR | 8.3 × 104 ± 0.64 b | 6.6 × 104 ± 0.77 d | 1.1 × 104 ± 0.43 a |
| BDISO76MR | 8.8 × 104 ± 0.64 b | 4.4 × 104 ± 0.77 e | 1.1 × 104 ± 0.43 a |
| Level of significance * | * | * | * |
| LSD | 5.87 | 1.37 | 1.33 |
| CV% | 0.12 | 0.08 | 0.41 |
| Treatments | Colony Forming Units (×106 CFU/g Root Tissue) 1 |
|---|---|
| Untreated control | 22.6 ± 1.3 d |
| BDISO76MR | 82 ± 0.0 a |
| BDISO01RR | 15.3 ± 0.6 e |
| BDISO36PR | 3 ± 0.0 f |
| BDISO45PR | 26.3 ± 0.3 c |
| BDISO49PR | 51.6 ± 0.3 b |
| Level of significance * | * |
| CV% | 2.29 |
| LSD | 1.96 |
| Treatment | Days after Sowing (DAS) | Vigor Index | |||||||
|---|---|---|---|---|---|---|---|---|---|
| 7 | 14 | 21 | 7DAS | 14DAS | 21DAS | ||||
| Root Length | Shoot Length | Root Length | Shoot Length | Root Length | Shoot Length | ||||
| (cm) | (cm) | (cm) | (cm) | (cm) | (cm) | ||||
| Untreated control | 16 ± 0.67 | 9.5 ± 0.83 | 35.5 ± 2.17 a | 44.67 ± 2.33 a | 33.33 ± 6.33 | 44.17 ± 7.83 | 2550 | 8016.67 | 7750 |
| BDISO76MR | 15.67 ± 1.00 | 8 ± 2.33 | 34.17 ± 2.83 a | 45 ± 1.00 a | 39.67 ± 3.00 | 53.67 ± 1.33 | 2366.67 | 7916.67 | 9333.33 |
| BDISO01RR | 23 ±8.00 | 8.83 ± 0.83 | 34 ± 3.00 a | 47.67 ± 3.00 a | 34.67 ± 1.00 | 55.67 ± 1.33 | 3183.33 | 8166.67 | 9033.33 |
| BDISO36PR | 18 ±1.67 | 13.17 ± 3.17 | 31.5 ± 1.83 a | 40.33 ± 2.33 a | 34 ± 4.00 | 53.17 ± 3.5 | 3116.67 | 7183.33 | 8716.67 |
| BDISO45PR | 18.17 ±1.67 | 9.83 ± 0.17 | 19.83 ± 0.5 b | 26.83 ± 0.17 b | 38.83 ± 1.17 | 58.8 ± 2.83 | 2800 | 3888.73 | 8138.89 |
| BDISO49PR | 18.17 ± 1.5 | 9.17 ± 0.17 | 31.17 ± 0.17 ab | 43 ± 2.00 a | 34.67 ± 3.67 | 60 ± 0.33 | 2733.33 | 7416.67 | 9466.67 |
| Level of significance * | NS | NS | * | * | NS | NS | - | - | - |
| LSD | 11.86 | 5.81 | 7.11 | 7.05 | 12.71 | 13.05 | - | - | - |
| CV% | 0.17 | 0.18 | 0.08 | 0.06 | 0.13 | 0.003 | - | - | - |
Publisher’s Note: MDPI stays neutral with regard to jurisdictional claims in published maps and institutional affiliations. |
© 2022 by the authors. Licensee MDPI, Basel, Switzerland. This article is an open access article distributed under the terms and conditions of the Creative Commons Attribution (CC BY) license (https://creativecommons.org/licenses/by/4.0/).
Share and Cite
Mita, M.M.; Jannat, M.; Bashar, S.; Protic, I.A.; Saha, P.; Masud, M.M.; Islam, R.; Islam, N.B.; Alam, M.Z.; Islam, M.R. Potential Native Bacilli Reduce Fumonisin Contamination in Maize. Agronomy 2022, 12, 2608. https://doi.org/10.3390/agronomy12112608
Mita MM, Jannat M, Bashar S, Protic IA, Saha P, Masud MM, Islam R, Islam NB, Alam MZ, Islam MR. Potential Native Bacilli Reduce Fumonisin Contamination in Maize. Agronomy. 2022; 12(11):2608. https://doi.org/10.3390/agronomy12112608
Chicago/Turabian StyleMita, Mamuna Mahjabin, Muhtarima Jannat, Samrin Bashar, Ismam Ahmed Protic, Plabon Saha, Md. Mostafa Masud, Rummana Islam, Nazia Binta Islam, Md. Zahangir Alam, and Md. Rashidul Islam. 2022. "Potential Native Bacilli Reduce Fumonisin Contamination in Maize" Agronomy 12, no. 11: 2608. https://doi.org/10.3390/agronomy12112608
APA StyleMita, M. M., Jannat, M., Bashar, S., Protic, I. A., Saha, P., Masud, M. M., Islam, R., Islam, N. B., Alam, M. Z., & Islam, M. R. (2022). Potential Native Bacilli Reduce Fumonisin Contamination in Maize. Agronomy, 12(11), 2608. https://doi.org/10.3390/agronomy12112608

